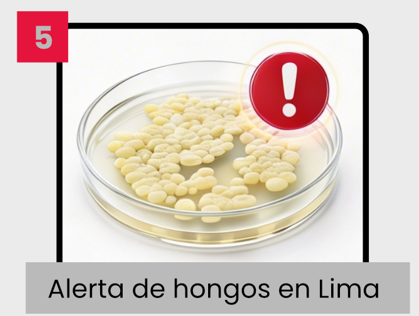
5

Publicaciones indizadas en Scopus: enero-marzo 2026
01Drone-based geospatial prediction modeling…
Drone-based geospatial prediction modeling identifies Fasciola hepatica infection risk in the Cusco Highlands of Peru
DOI https://doi.org/10.1186/s40249-026-01420-1
DOI https://doi.org/10.1186/s40249-026-01420-1
02Assessing the diagnostic performance…
Assessing the diagnostic performance of clinical, serological and molecular approaches to improve dengue case detection in the Peruvian Amazon
DOI https://doi.org/10.1371/journal.pntd.0013984
DOI https://doi.org/10.1371/journal.pntd.0013984
03Dosing and safety of amphotericin B…
Dosing and safety of amphotericin B deoxycholate in paediatric American cutaneous leishmaniasis in Peru: a case series
DOI https://doi.org/10.1186/s12879-025-12344-w | Conoce más
DOI https://doi.org/10.1186/s12879-025-12344-w | Conoce más
04LAMP-coupled CRISPR-Cas12a assays…
LAMP-coupled CRISPR-Cas12a assays: A promising new tool for molecular diagnosis of leishmaniasis
DOI https://doi.org/10.1371/journal.pntd.0013456
DOI https://doi.org/10.1371/journal.pntd.0013456
05First draft genome sequence…
First draft genome sequence of Candidozyma auris from a human clinical isolate in a major metropolitan hospital in Lima, Peru
DOI https://doi.org/10.1128/mra.00538-25 | Conoce más
DOI https://doi.org/10.1128/mra.00538-25 | Conoce más
06Genomic features of pneumococcal strains…
Genomic features of pneumococcal strains isolated from paediatric patients with invasive disease during pneumococcal conjugate vaccine introduction in Lima, Peru
DOI https://doi.org/10.1099/mgen.0.001621 | Conoce más
DOI https://doi.org/10.1099/mgen.0.001621 | Conoce más
07Epidemiology of adult T-cell leukemia…
Epidemiology of adult T-cell leukemia/lymphoma (ATL) in people living with HTLV-1: A 30-year study in Peru
DOI https://doi.org/10.1371/journal.pntd.0014010 | Conoce más
DOI https://doi.org/10.1371/journal.pntd.0014010 | Conoce más
08Genomic surveillance of multidrug-resistant…
Genomic surveillance of multidrug-resistant Escherichia coli and Klebsiella in clinical and wastewater isolates from a paediatric hospital in Lima, Peru
DOI https://doi.org/10.1099/acmi.0.001006.v3 | Conoce más
DOI https://doi.org/10.1099/acmi.0.001006.v3 | Conoce más
